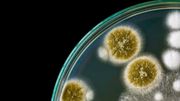
Aumenta en EE. UU. la amenaza de bacterias resistentes a los antibióticos

EEUU

¿Por qué los demócratas advierten sobre las órdenes ilegales de Trump?
El presidente Donald Trump ha vuelto a sugerir que sus oponentes políticos merecen ser ejecutados. Y, una vez más, basa su argumento en una teoría legal bastante novedosa y una interpretación dudosa de los hechos.